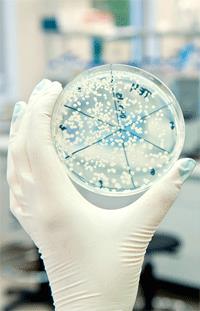
The Top Germ Hot-Spots That Could Affect Your Health

12 February 2015 | Citron Hygiene UK Ltd
The Top Germ Hot-Spots That Could Affect Your Health
Washroom and Hygiene Germs are all around us (and on us!) and on every surface you can imagine. There are some obvious culprits, such as toilets, door handles and rubbish bins that can all harbour infectious viruses and bacteria. However, there are also many common and every-day surfaces that can be a haven for these illness-inducing bugs and germs. Recent research has found that the popular germ hotspots include money, can-openers, kitchen cloths, office keyboards and - perhaps surprisingly -
MoneyBy the time money reaches your hands, it could have come into contact with about 100 people − and their germs. A study conducted by the London School of Hygiene & Tropical Medicine, found that bank notes showed ‘gross contamination’ of bacteria, including E.coli and Staphylococci.
Their results showed that faecal contamination of bank notes and credit cards is an every-day threat that good hand washing can dramatically reduce. So, when it comes to money − be it cards, notes or coins, always wash your hands after handling.
Can openers
If you fancy a warming tin of soup this winter, you might want to check the last time the can opener was thoroughly washed. In a 2013 Germ Study by NSF International, 14 common kitchen items were tested for the presence of four different types of microorganisms: E. coli, Salmonella, yeast and mould, and Listeria. It found that the humble can opener tested positive for Salmonella, E.coli, yeast and mould.
Kitchen cloths
Spraying down surfaces with an antibacterial cleaner can be a pointless exercise if the kitchen cloth is contaminated with germs. Used for everything from wiping dishes to cleaning worktops, the average kitchen cloth or sponge has been identified as ‘the dirtiest thing by far in the kitchen’, according to Professor John Oxford, Chair of the Hygiene Council. In a survey, nine of out 10 dishcloths were found to have unsatisfactory levels of bacteria. A good alternative is to use disposal paper towels to wipe down surfaces as they can be binned immediately after use.
Office keyboards
When was the last time you cleaned your keyboard? Chances are, it hasn’t been cleaned at all as people don’t tend to think about it as being particularly dirty. But, as keyboards can reportedly carry as many as 200 times the amount of bacteria found on a toilet seat, it’s important that they are regularly wiped down with a suitable antibacterial cleaner.
Pillows
The bedroom is meant to be a tranquil area for rest and relaxation but you might not be so willing to rest your head if you knew your pillow was harbouring dirt, dead skin cells and dust mites. Advice by the Hygiene Council recommends weekly washing of bed linen and pillows at 60 degrees in order to kill dust mites and remove bacteria.
The fact is that whilst we can’t avoid germs, we can all follow good hygiene practice and protect ourselves and those around us from infections and illnesses. For more information or to stay up to date with the latest hygiene and infection news please contact Cannon Hygiene or follow us on Twitter or LinkedIn.